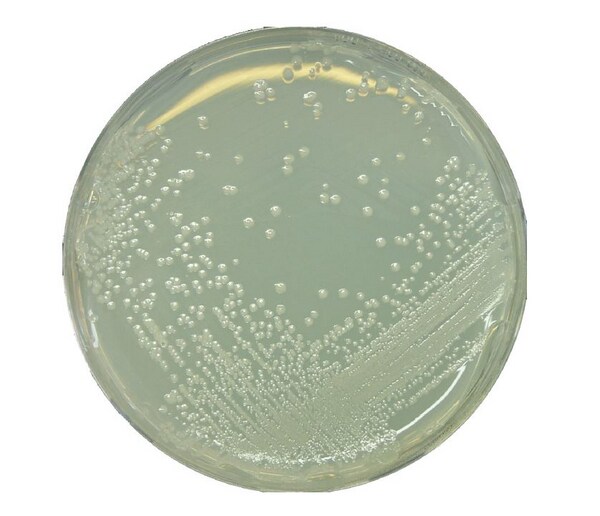
1079940500.JPG

* Imagem meramente ilustrativa
AGAR BAT MEDIUM MERCK (EMB 500 GR)
Modelo: 1079940500
R$ 1.833,05
ou até 3x de R$ 611,02 sem juros
Economize 5% no PIX: R$ 1.741,40
ou 3,5% no boleto: R$ 1.768,89
Calcular Frete
Descrição
BAT MEDIUM MERCK
RENDIMENTO 14,5g/l P/ DETECÇÃO ALICYCLOBACILLUS
EMBALAGEM 500G
Medium for the detection of Alicyclobacillus in Fruit Juices.
Alicyclobacilli are aerobe, gram-positive spore forming bacteria, whose optimum of growth is at low pH value and increased temperatures. Alicyclobacilli are spoilage organisms especially effecting the quality of fruit juices. (CERNY et al. 1984, BAUMGART und MENJE 2000).
The Medium complies with First Standard IFU-Method on the Detection of Alicyclobacillus in Fruit Juices (2003).
Mode of Action
The BAT Medium supports the growth of Alicyclobacilli.The low pH-value in combination with the high incubation temperature inhibit the contaiminating flora in growth.
Typical Composition (g/litre)
Yeast extract 2.0; D(+)glucose 5.0; Calcium chloride 0.25; Magnesium sulfate 0.5; Ammonium sulfate 0.2; Potassium-dihydrogenphosphate 3.0; Zinc sulfate 0.00018; Copper sulfate 0.00016; Manganese sulfate 0.00015; Cobalt-chloride 0.00018; Boric acid 0.00010; Sodium molybdate 0.00030; Agar-Agar 18.0.
